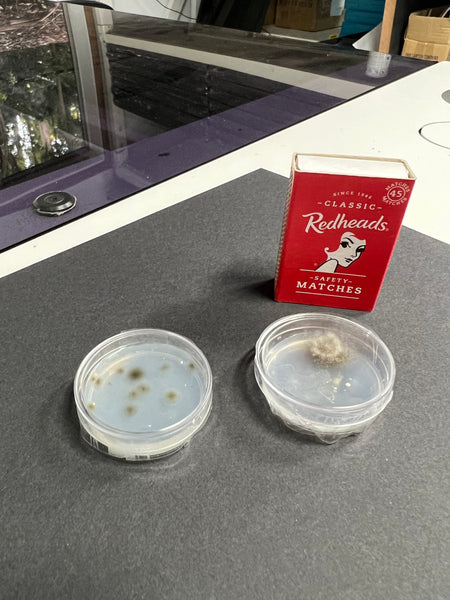

Sterile Plastic Petri Dishes - Pack of 10 - Diameter 4cm
Regular price
$5
Tax included.
Shipping calculated at checkout.
Why oh why would you keep using the regular 9cm petri dishes for a class of year 9 kids when these small petri dishes will grow the bacteria and fungi just as well!
You'll be able to fit them all into your incubator, and then pop the lot into the pressure cooker when done.
It's time to think TINY people!
This product is for a set of 10 complete sterile petri dishes (lid and base).
These little petri dishes can be used for so much more than just growing bad stuff.
They can be used as insect holders, or even dispensing chemicals to the students.
The petri dishes have a diameter of 40mm and height of 13mm.